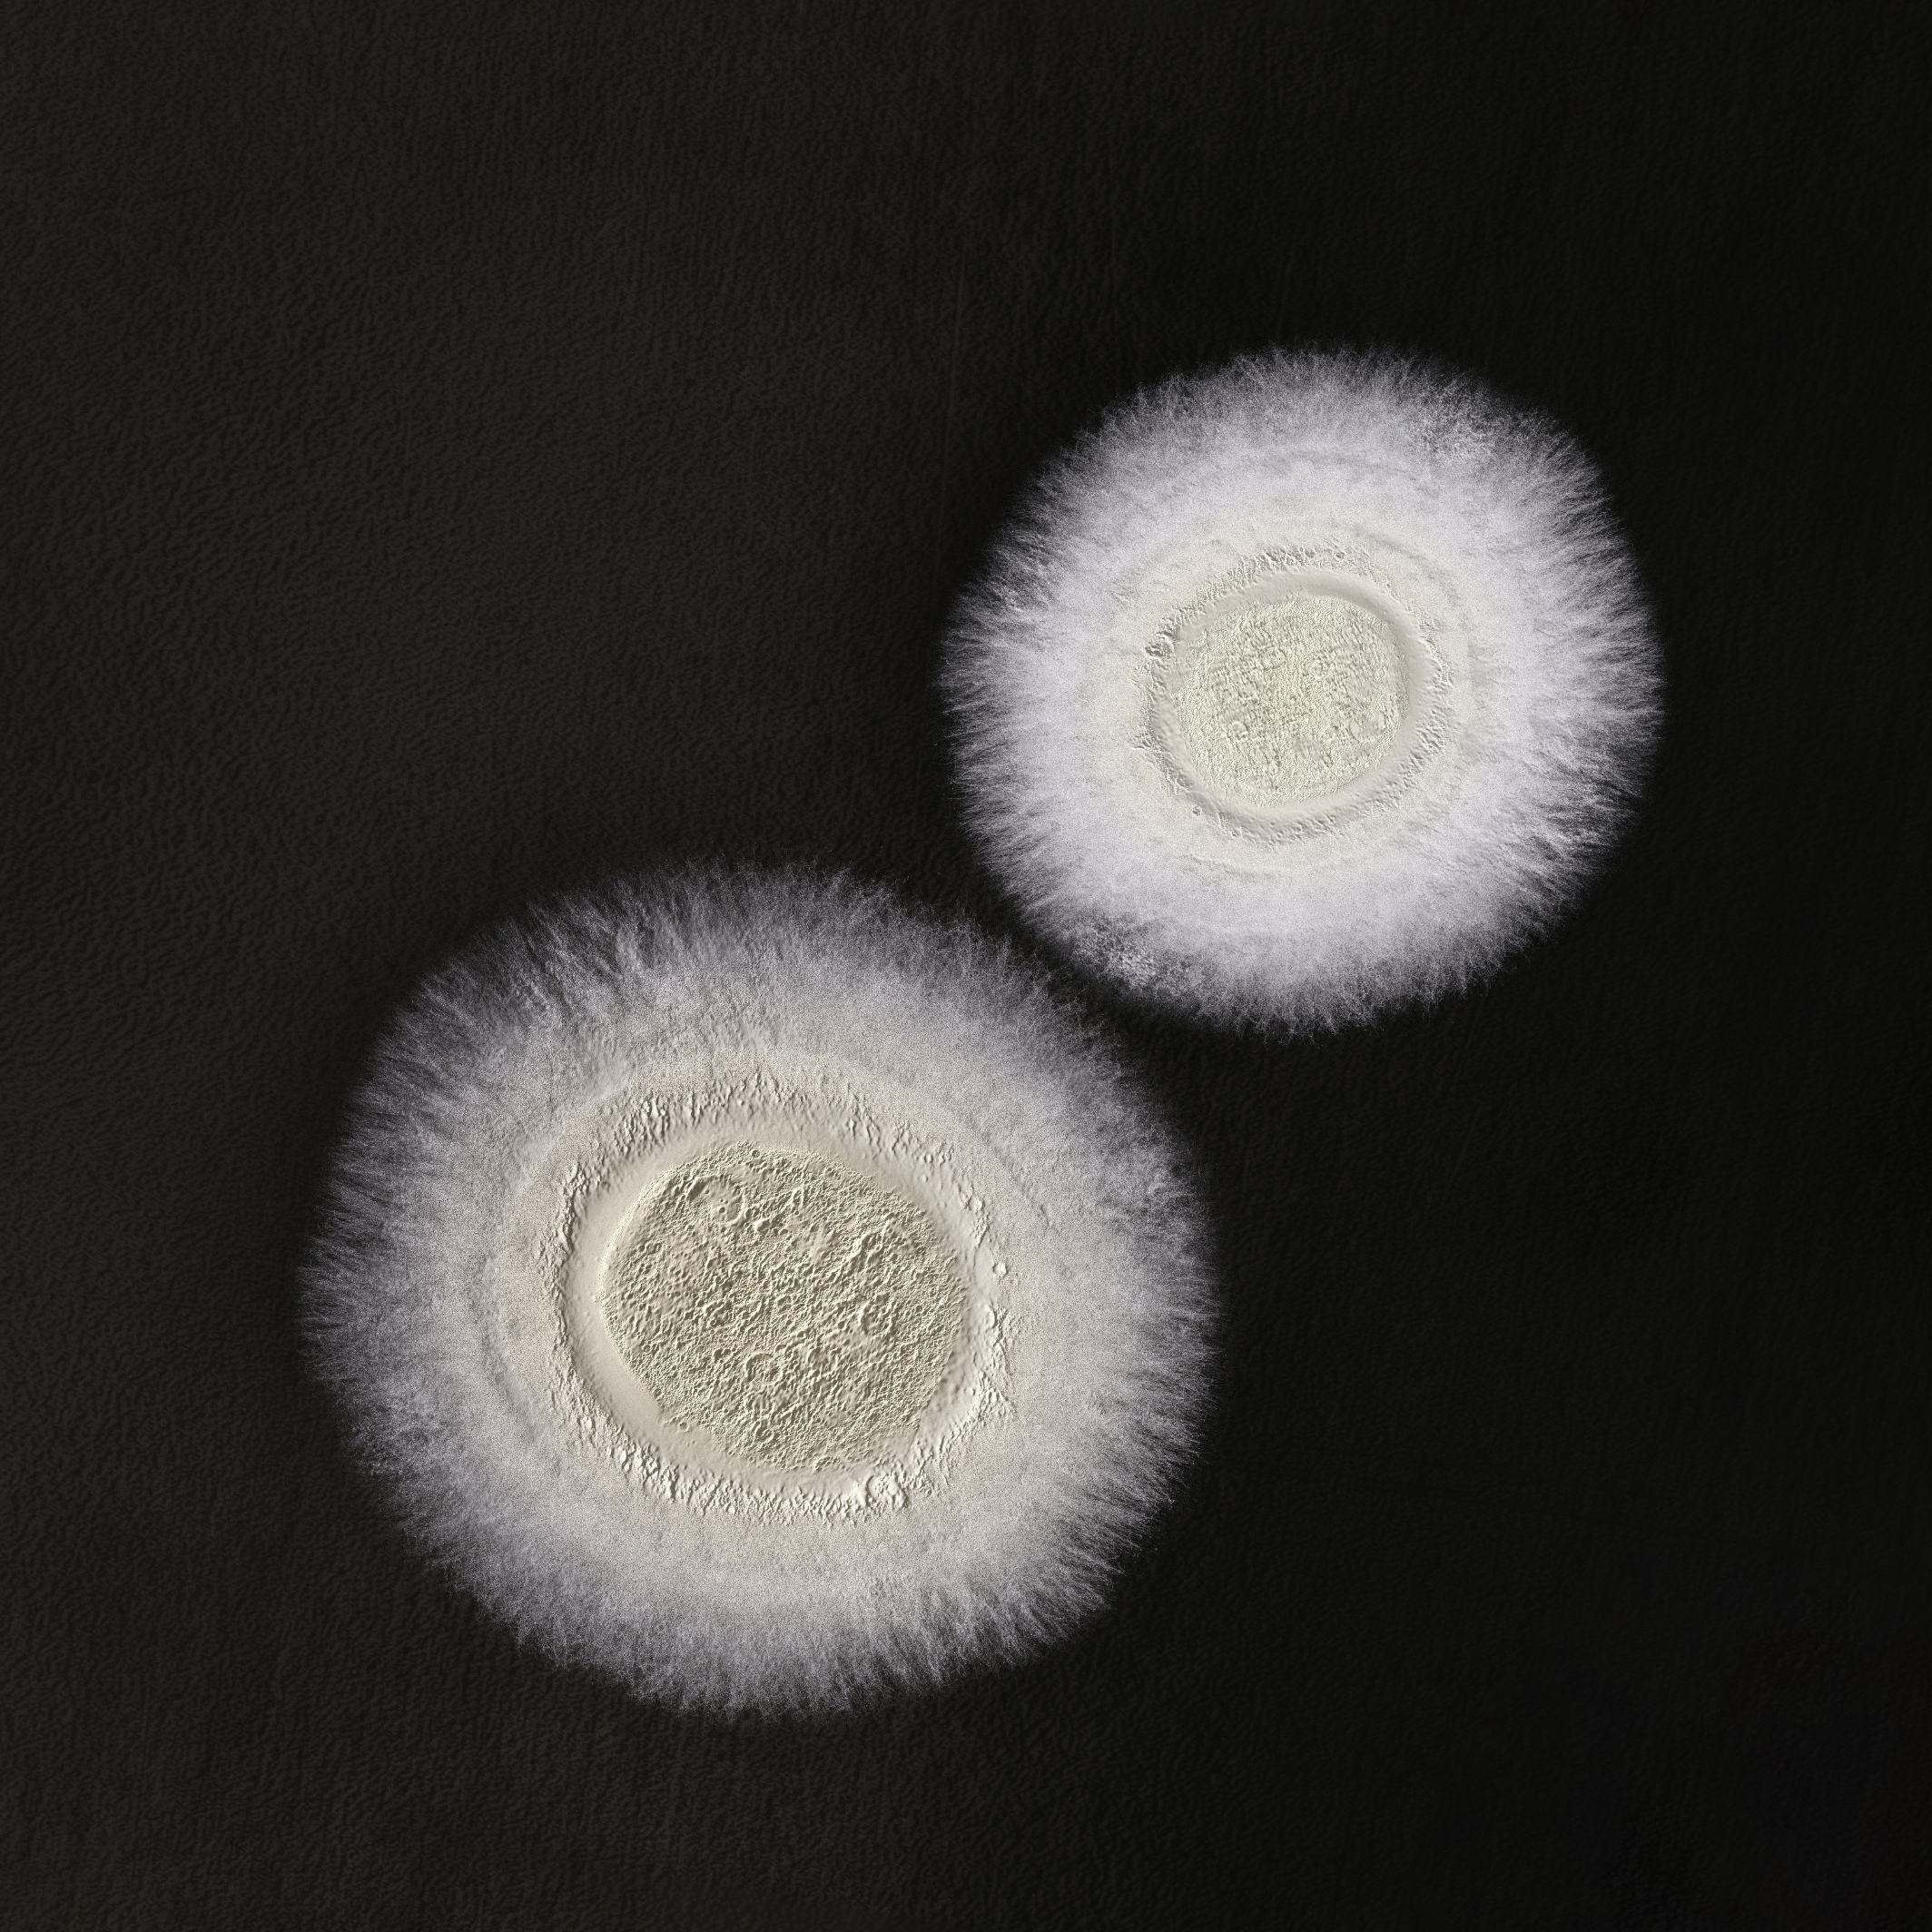

Aplicación
APLICACIÓN AÉREA:
- Limpiar muy bien el tanque / boquillas del pulverizador para eliminar residuos de insecticidas, herbicidas o fungicidas químicos.
- Llenar con agua 2/3 del depósito del pulverizador. Paralelamente, disolver cada 1 kg del producto en 20 litros de agua, usando un balde limpio como recipiente. Agitar con intensidad hasta que el caldo se vuelva homogéneo.
APLICACIÓN TERRESTRE:
- Aplicado en forma líquida, por medio de pulverizadores de barra o costal, con el chorro de pulverización dirigido a la base de la planta, pudiendo ser adaptado con todo tipo de abanico.
Pulverización:
- Limpiar muy bien el tanque / boquillas del pulverizador para eliminar residuos de insecticidas, herbicidas o fungicidas químicos.
- Llenar con agua 2/3 del depósito del pulverizador. Paralelamente, disolver cada envase (1 kg) del producto en 20 litros de agua, usando un balde limpio como recipiente. Agitar con intensidad hasta que el caldo se vuelva homogéneo. Se recomienda aplicar en las horas más frescas del día.